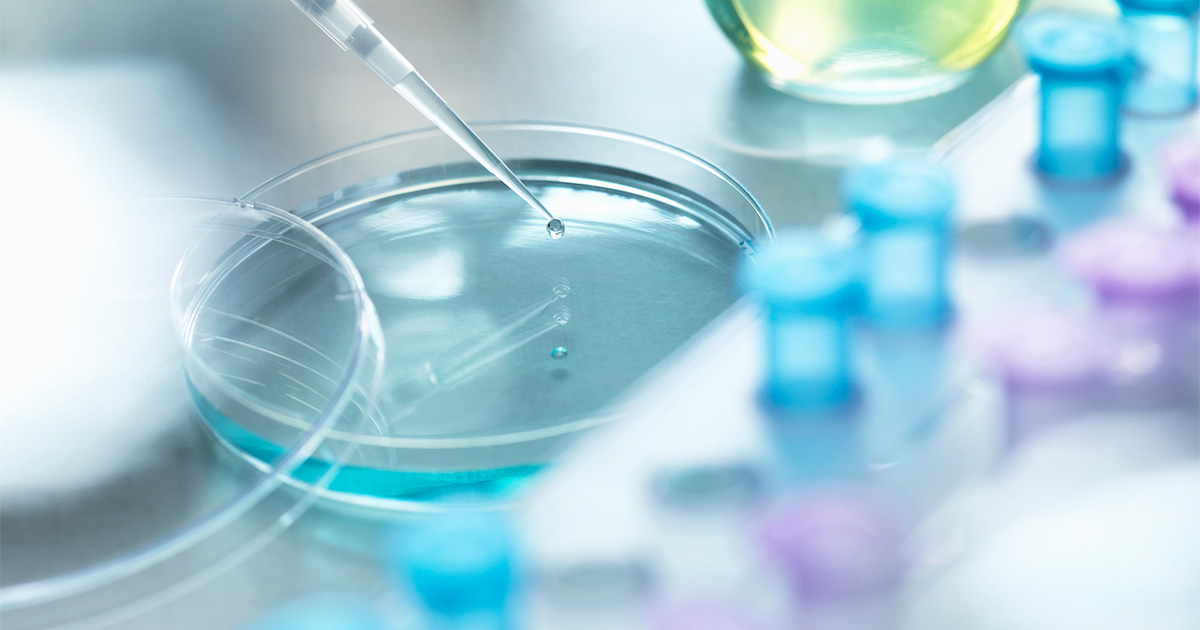

安全性試験関連
日本薬局方マイコプラズマ否定試験に利用可能なマイコプラズマ否定試験用液体培地、およびマイコプラズマ遺伝子検出キット Myco Finder 、高感度かつ迅速なウイルス否定試験試薬をご紹介いたします。
受託サービス
オリジナル組成の培地を作りたい、より培養効率のよい培地のヒントを知りたい、
NAT試薬を導入したいが測定できるかわからない…そんなお悩みはありませんか?
島津ダイアグノスティクスが解決のお手伝いをさせていただきます!
セミナーアーカイブ
過去に開催したセミナーの映像をご視聴いただけます。
※動画の視聴にはパスワードの入力が必要です。パスワードはこちらまでお問い合わせください。